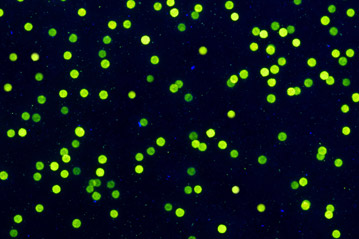

W zależności rodzaju materiału wykorzystanego do produkcji druków zabezpieczonych, PWPW stosuje różne rodzaje zabezpieczeń. Niektóre są charakterystyczne tylko dla banknotów oraz dokumentów na podłożu papierowym, inne dla dokumentów tworzywowych.
Projektując i produkując dokumenty, nasza firma oferuje, w zależności od typów podłoża, następujące zabezpieczenia:
PWPW posiada szeroką gamę rozwiązań stosowanych w warstwie elektronicznej dokumentów. Służą one do przechowywania danych użytkownika i zapewnienia ich bezpieczeństwa, a także umożliwiają wykorzystanie dokumentów elektronicznych w nowoczesnych usługach, procesach i transakcjach elektronicznych.
PWPW
SmartApp®
Produkty PWPW
SmartApp® są wykorzystywane w kartach i dokumentach elektronicznych, takich jak paszporty biometryczne, elektroniczne dowody osobiste, legitymacje oraz karty kryptograficzne. Rozwiązania PWPW SmartApp® składają się ze specjalistycznego oprogramowania (tzw. apletu) opracowanego przez programistów PWPW, systemu operacyjnego oraz specjalnego mikroprocesora dedykowanego dla zastosowań wymagających dużego poziomu bezpieczeństwa. Zastosowana technologia zapewnia najwyższy poziom ochrony przechowywanych danych oraz oferuje szerokie możliwości wykorzystania produktów PWPW
SmartApp® w usługach i transakcjach elektronicznych, oferuje także większe możliwości dla użytkowników oraz organów kontroli.
PWPW SmartApp-ID
Produkty z rodziny PWPW SmartApp-ID są przeznaczone do paszportów biometrycznych oraz elektronicznych kart pobytu dla cudzoziemców, mogą być także stosowane w pozostałych rodzajach dokumentów tożsamości.
Mechanizmy bezpieczeństwa zaimplementowane w tym produkcie chronią w szczególności integralność i autentyczność przechowywanych danych, zapobiegają przed ich fałszowaniem i nieautoryzowanym odczytem, umożliwiają także przeprowadzenie szybszej kontroli imigracyjnej i lepszą ochronę granic.
W rozwiązaniu PWPW SmartApp-ID 3.1 (IFX) zaimplementowano najnowszy mechanizm Supplemental Access Control (SAC), który zgodnie z wymogami Komisji Europejskiej musi być stosowany we wszystkich paszportach i kartach pobytu wydawanych od początku 2015 roku oraz jest rekomendowany przez organizację International Civil Aviation Organization (ICAO) do stosowania w paszportach elektronicznych na całym świecie. Produkt PWPW SmartApp-ID 3.1 (IFX) z rozwiązaniem SAC otrzymał w 2014 roku prestiżowy certyfikat Common Criteria.
PWPW SmartApp-ID 3.1 (IFX) jest stosowany od początku 2015 roku w paszporcie polskim oraz polskiej karcie pobytu dla cudzoziemców. Produkty z rodziny SmartApp-ID wykorzystywane są również w dokumentach Republiki Litwy oraz Armenii.
PWPW SmartApp-CRYPTO
Produkty z rodziny PWPW SmartApp-CRYPTO przeznaczone są do zastosowań kryptograficznych, takich jak podpis elektroniczny, szyfrowanie danych oraz uwierzytelnienie w systemach informatycznych. Produkty mogą być wykorzystane w kartach kryptograficznych, legitymacjach i kartach korporacyjnych. Najnowszy produkt PWPW SmartApp-CRYPTO 3.0 poza wymienionymi funkcjonalnościami pozwala również na bezpieczne przechowywanie danych użytkownika w specjalnym systemie plików oraz obsługuje technologię Mifare, dedykowaną dla kart miejskich oraz kart dostępowych. PWPW SmartApp-CRYPTO nie wymaga używania dodatkowego oprogramowania middleware – jest obsługiwany bezpośrednio przez systemy Microsoft Windows. Produkt jest zgodny ze specyfikacją techniczną Microsoft Generic Identity Device Specification.
Biometria – wykorzystywana jest zarówno w systemach IT, wspierających procesy personalizacji kart eID oraz ePaszportów, jak i w samych dokumentach, wprowadzając dodatkową linię zabezpieczeń niezmiernie trudną do obejścia. PWPW dysponuje wiedzą, zapleczem technologicznym oraz potwierdzonymi referencjami dla projektów wykorzystujących techniki biometryczne w Polsce (polski system paszportowy) i na świecie (Armenia – system dowodowy i paszportowy, Litwa – system paszportowy, Bangladesz – system paszportowy). Dodatkowo PWPW dysponuje rozwiązaniem typu AFIS do centralnej obsługi danych biometrycznych, w tym zapisu danych do centralnej bazy danych i udostępniania usług weryfikacji i identyfikacji, a także oceny jakościowej danych biometrycznych: odcisków palca i zdjęcia twarzy. W ramach prac badawczo-rozwojowych PWPW rozwija ten element zabezpieczenia poprzez udział w projektach dla Straży Granicznej, a także w ramach wewnętrznych prac nad automatycznymi mechanizmami rozpoznawania cech biometrycznych.
PWPWTrace® - jest szczególnym rodzajem zabezpieczenia systemowego - to wielofunkcyjna platforma, która zapewnia śledzenie produktów na każdym etapie łańcucha dostaw: od producenta aż do ostatniego punktu detalicznego. Zabezpiecza nie tylko produkt poprzez oznaczanie go unikalnym kodem, ale gwarantuje także integralność łańcucha dostaw. PWPW.trace jest jedynym w swoim rodzaju systemem zabezpieczeń IT, pozwalającym na skuteczną weryfikację autentyczności produktu i jego śledzenie, a także umożliwiającym skuteczne zwalczanie obrotu towarami podrobionymi. Rozwiązanie to spełnia potrzeby potencjalnych klientów (krajowych i zagranicznych) z branży tytoniowej, farmaceutycznej, spożywczej, kosmetycznej, a także firm, których celem szczególnym jest ochrona marki. System spełnia wymagania m.in. dyrektywy UE w zakresie śledzenia wyrobów tytoniowych.
PKI / e-Podpis – PWPW posiada własną Infrastrukturę Klucza Publicznego (PKI), niezbędną do świadczenia usług certyfikacji elektronicznej, m.in. wydawania kwalifikowanych certyfikatów oraz znakowania czasem. Oferujemy systemy transakcyjne wykorzystujące własne produkty technologiczne i integrujemy je z rozwiązaniami posiadanymi przez klientów. Produkty PKI oferowane są zarówno w modelu usługowym, jak i wdrożeniowym. Podstawową funkcją e-podpisu jest zabezpieczenie autentyczności dokumentu elektronicznego.
Mikroprocesor dualny (dual interface) – produkty PWPW przeznaczone do kart i dokumentów mogą, w zależności od zastosowania, wykorzystywać różne interfejsy komunikacyjne: stykowy, bezstykowy lub obydwa jednocześnie – czyli interfejs dualny. PWPW posiada technologię pozwalającą na produkcję wszystkich wymienionych rodzajów kart i dokumentów, w tym nowoczesnych kart dualnych np. dla sektora bankowego.